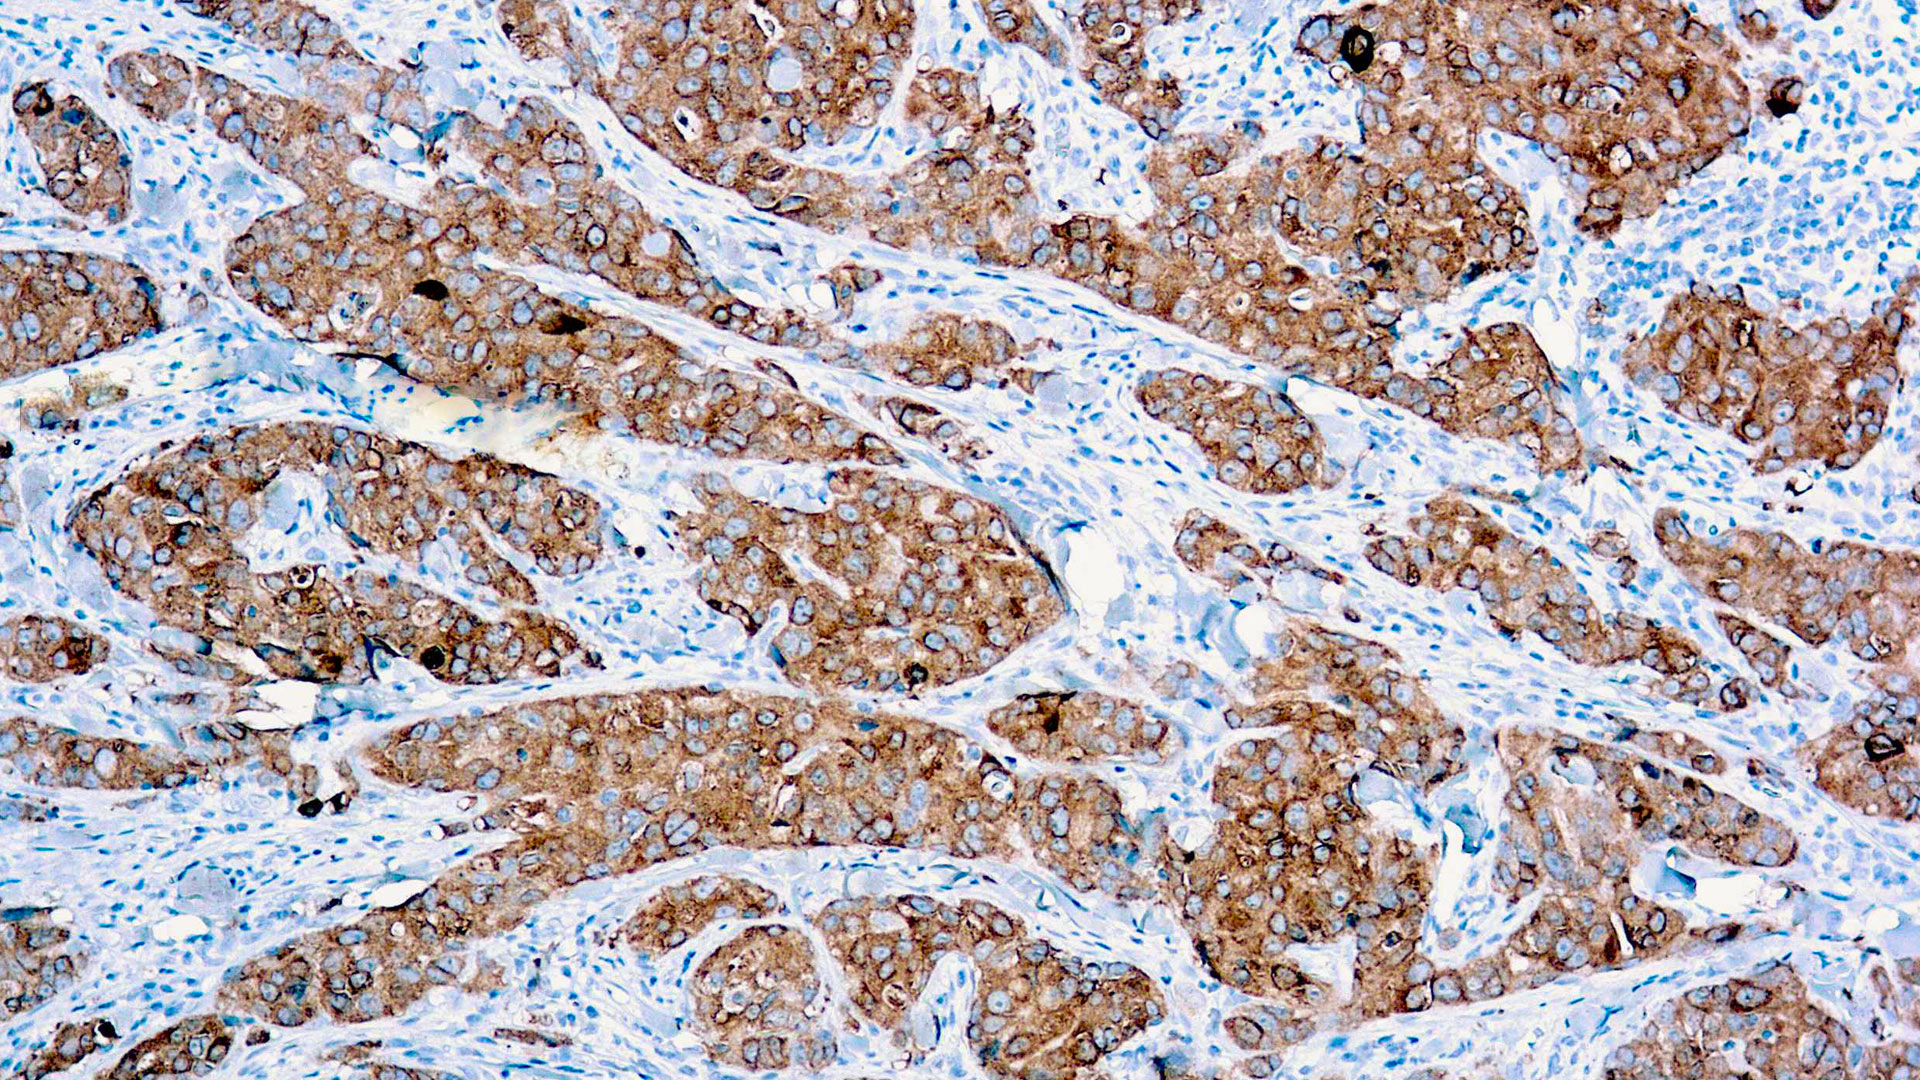

MUC1/ CA 15-3
Description
This MAb reacts with MUC1. The dominant epitope of this MAb has not yet been determined. MUC1 is a large cell surface mucin glycoprotein expressed by most glandular and ductal epithelial cells and some hematopoietic cell lineages. It is expressed on most secretory epithelium, including mammary gland and some hematopoietic cells. It is expressed abundantly in lactating mammary glands and over expressed abundantly in >90% breast carcinomas and metastases. Transgenic MUC1 has been shown to associate with all four c-erbB receptors and localize with c-erbB1 (EGFR) in lactating glands. The MUC1 gene contains seven exons and produces several different alternatively spliced variants. The major expressed form of MUC1 uses all seven exons and is a type 1 transmembrane protein with a large extracellular tandem repeat domain. The tandem repeat domain is highly O glycosylated and alterations in glycosylation have been shown in epithelial cancer cells. Antibody to EMA is useful as a pan-epithelial marker for detecting early metastatic loci of carcinoma in bone marrow or liver.
Additional information
| Catalog No. | Mob549 Concentrated, PDM549 Prediluted |
|---|---|
| Clone | DBMM1 |
| Isotype | IgG1, kappa |
| Immunogen | Human breast cancer cell line ZR-75-1 |
| Species | Mouse |
| Cellular Localization | cell membrane, Cytoplasmic |
| Positive Control Tissue | Breast carcinoma |
| Pretreatment | EDTA Buffer pH 8.0 |
| Incubation & Temperature | 30 min @ RT |
| Intended Use | IVD |
| Detection System | PolyVue Plus – Two Step Detection System or Montage PolyVue Plus Auto Detection System for Montage 360 System |
| Description/Type | Mouse Monoclonal Antibody |
| Format | Tissue Culture Supernatant |
DATASHEETS & SDS
DATASHEETS & SDS
| Download Datasheet |
| Download SDS Sheet – OSHA |
REFERENCES
REFERENCES
- Hilkens, J., Buijs, F., Hilgers, J., Hageman, P., Calafat, J.,
Sonnenberg, A. and van der Valk, M. 1984. Monoclonal
antibodies against human milk-fat globule membranes
detecting differentiation antigens of the mammary gland and
its tumors. Int. J. Cancer 34: 197-206.
Reviews (0)
Only logged in customers who have purchased this product may leave a review.

Reviews
There are no reviews yet.